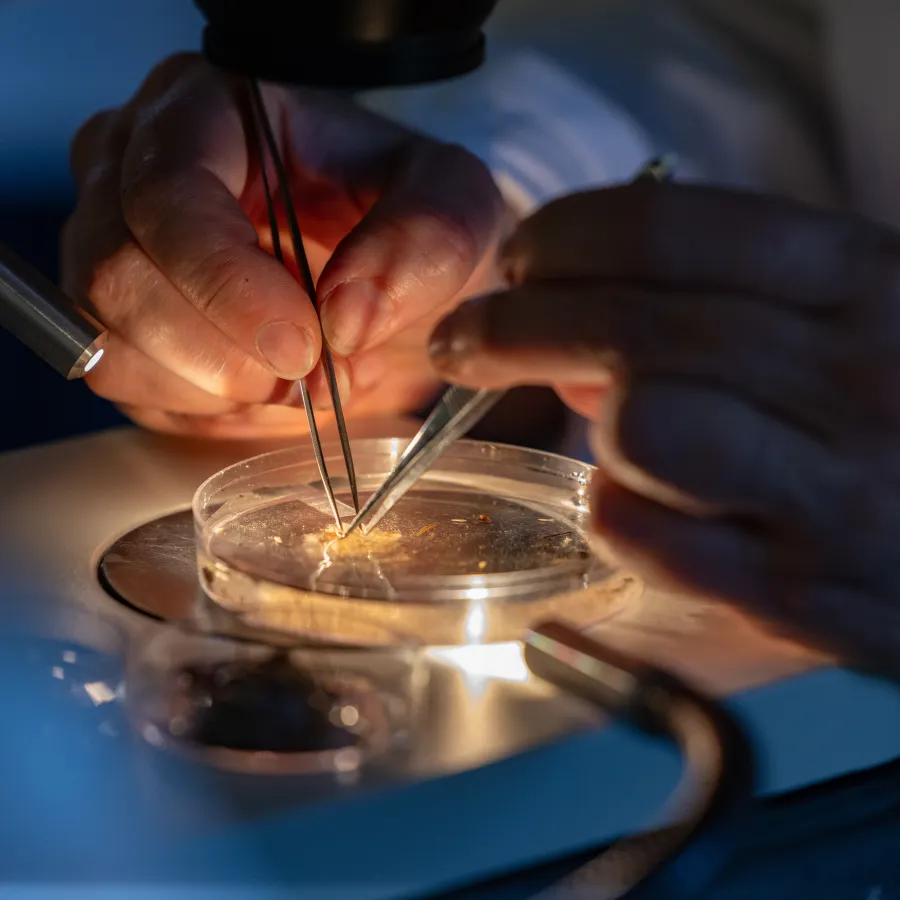

Supporting Students in STEM
Research & Inquiry
Three Smith College students have been named 2026 Goldwater Scholars, a highly prestigious recognition for undergraduate researchers
Photos by Jessica Scranton
Published April 27, 2026
For Ada Comstock Scholar Mary-Alice Wieland, being awarded a Goldwater scholarship to support her research in STEM is an important “signifier” to graduate schools and future colleagues that “I’m serious about research.”
Fellow recipient Ashley Cheng ’27 says she looks forward to joining a community of scholars who are “super passionate about research.”
And for Sophia Liu ’27, being selected as Smith’s third 2026 Goldwater scholar “means that someone else believes in me. It’s an encouragement.”
The three Smith students were selected for the prestigious scholarship from an estimated pool of more than 5,000 college sophomores and juniors nominated by 482 academic institutions. The Goldwater Scholarship and Excellence in Education Foundation—named in honor of the late Senator Barry Goldwater—provides up to $7,500 annually to students pursuing research careers in STEM. The 2026–27 cohort includes 454 students interested in medicine, engineering, computer science, and other STEM disciplines.
Smith has achieved notable success with the Goldwater program, with multiple students receiving scholarships in previous years.
“Since 2014, Smith has had one year with four students selected and two consecutive years with three students,” says Andrew Dausch, Smith’s director of Fellowships and Postgraduate Scholarships. “Having three of the five students we nominated chosen this year for scholarships speaks to the quality of our students, the mentorship they receive from faculty at Smith, and the strength of our science curriculum.”
Professor of Chemistry Kevin Shea, who has taught and mentored recent Goldwater recipients, says, “Our faculty’s willingness to help students start research early in their Smith careers has helped them become accomplished scientists as undergraduates.”
Fellow mentor Halie Rando, assistant professor of computer science, agrees that research is a valued part of education at Smith. “Our students are eager to explore how their coursework can have an impact beyond the classroom,” she says. “Research is one powerful way to do that, especially in a community where so many faculty members share those same values.”
Here’s what Smith’s three newest Goldwater Scholars had to say about their research and their scholarship awards.
Ashley Cheng ’27
Biochemistry major

Sophia Liu ’27
Biological sciences major

Mary-Alice Wieland AC
Computer science major